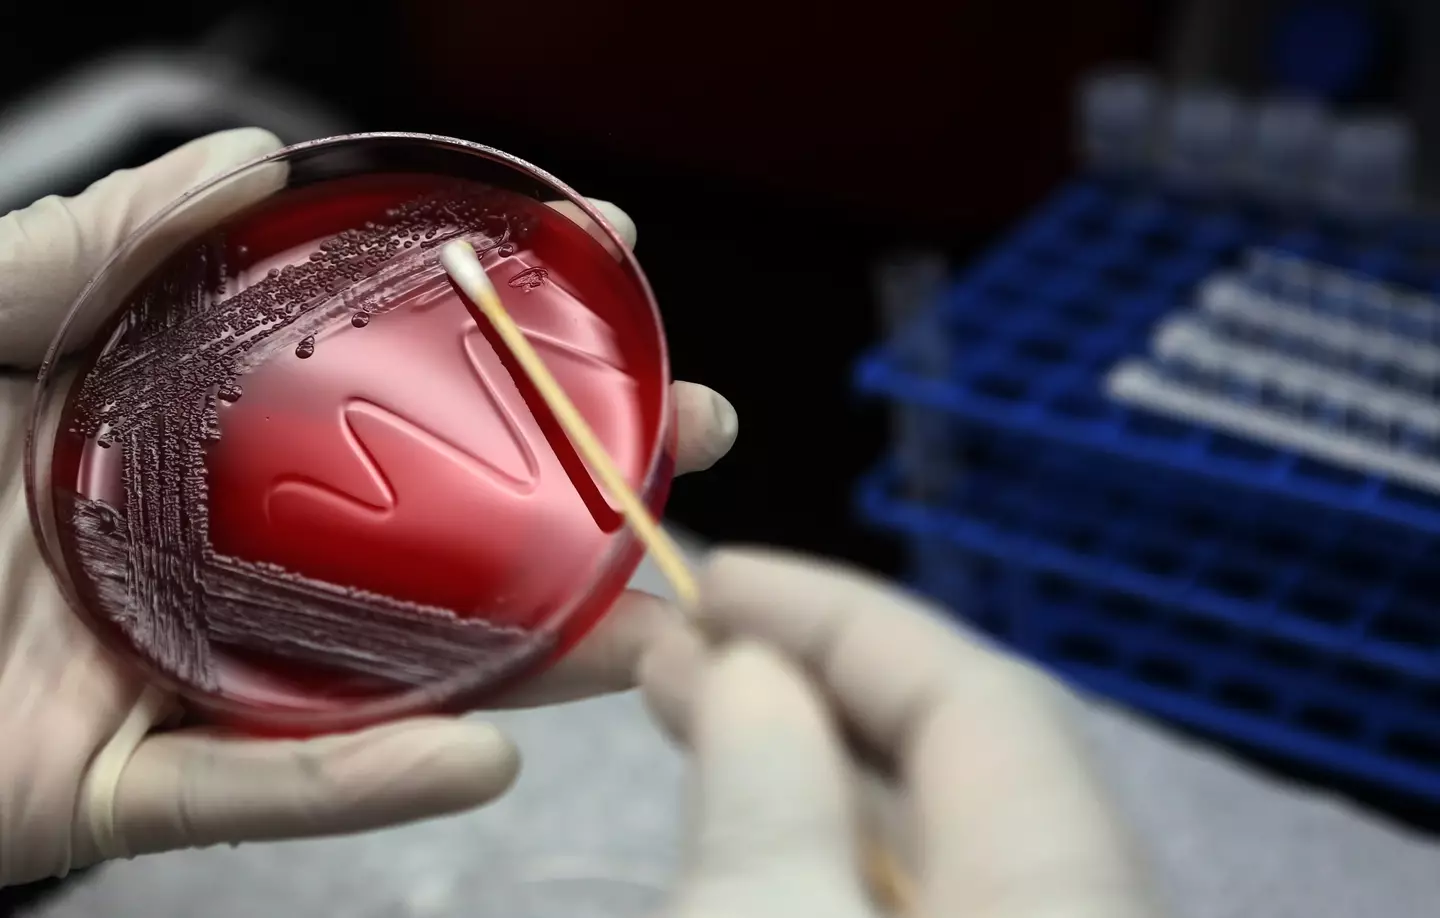
Routine tests for salmonella detected the bacteria's presence in one of the company's chocolate bars (Mayra Beltran/Houston Chronicle via Getty Images)

A luxury chocolate bar company has drastically increased the number of its products being urgently recalled after it was discovered that some had been contaminated by bacteria that can cause 'fatal infections'.
Chocolatier Spring & Mulberry, whose organic bars are sweetened with dates rather than refined sugars, feature a wide variety of flavors across their selection, but a number have been recalled over salmonella fears.
The foodborne bacteria, which is a particular threat to the very young and old as well as the immunocompromised, kills around 420 Americans each year and is a leading cause of food-related hospitalizations, according to the Center for Disease Control.
Initially, the business had issued a salmonella alert for their 'Mint Leaf' chocolate bars, but in an updated press release, January 14, they confirmed that a further seven products were included in the recall.
Advert

The North Carolina based company is continuing to urge any customers who have purchased an affected product to throw it away and not consume it.
Spring & Mulberry explained why they are expanding the recall, stating: "Because salmonella can be difficult to detect and may appear intermittently, we are now expanding the recall beyond Mint Leaf in consultation with the FDA to include additional production lots made during the same time period on the same equipment."
Which flavor Spring & Mulberry chocolate bars are being recalled?
Not every Spring & Mulberry product on the shelves is affected by this recall, only those batches of flavors made at the same time as the affected chocolate bar.
Recalled bars can be identified by their flavor name, color, and individual lot codes. This code is present on both the back of the passaging and the inner wrapping.
A full list of recalled bars and their lot codes can be found below.
- Earl Grey (Purple) #025258
- Lavender Rose (Light Blue) #025259, #025260
- Mango Chili (Rose) #025283
- Mint Leaf (Teal) #025255
- Mixed Berry (Purple) #025275, #025281, #025337
- Mulberry Fennel (Burgundy) #025345
- Pecan Date (Yellow) #025261, #025265, #025267, #025268, #025339, #025343
- Pure Dark Minis (Blue) #025273
When were Spring & Mulberry chocolate bars contaminated?
Only the products listed above are being recalled over potential cross-contamination fears.
Salmonella was first discovered in the Mint Leaf bars by a third-party firm carrying out routine testing at Spring & Mulberry's manufacturer, but the decision was taken to expand the recall notice to all other products made at the factory during the same dates.
The FDA confirmed that the affected Spring & Mulberry bars have been sold across the country since September 15, 2025. So, if you have one of the luxury chocolates in your cupboard, it's worth checking which batch it came from.
Where were contaminated Spring & Mulberry bars sold?
Any purchased bars with the correct lot code should be discarded, regardless of whether or not it looks, smells, or even tastes like regular chocolate. This is because salmonella mostly lives on surfaces, without necessarily spoiling the food product.
Chocolate from Spring & Mulberry that was either purchased online through their website, or through 'select retail partners' across the country, largely smaller alternative lifestyle stores and farmer's markets.
For those who want a refund on their purchase, the company advises: "Customers may request a refund or replacement by contacting Spring & Mulberry at [email protected] with a photo of the lot code."
Topics: Food and Drink, Health, US News